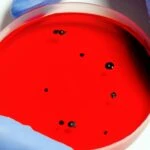
Adsiz tasarim 80 1

Boğaz ve kulak borusu kaşıntısı nasıl geçer? Kaşıntıya en hızlı gelen yöntem
Boğaz ve kulak borusu kaşıntısı son derece rahatsız edici sağlık problemleri arasındadır. Peki, boğaz ve kulak borusu kaşıntısı nasıl geçer? Kaşıntıya en hızlı gelen yöntem hangisi? İşte detaylar…



Sizde son zamanlarda boğaz ve kulak borusu kaşıntısından şikayetçiyseniz, doğru yerdesiniz. Artan viral hastalıklar ve salgınlarla birlikte çeşitli hastalıklarda kendini göstermeye başladı. Özellikle boğaz ve kulaklardaki kaşıntı genellikle alerji ve enfeksiyon kaynaklı meydana gelir. Peki, boğaz ve kulak borusu kaşıntısı nasıl geçer? Kaşıntıya en hızlı gelen yöntem hangisi? Boğaz ve kulak borusu kaşıntısı hakkında merak edilenleri sizin için araştırdık. İşte boğaz ve kulaklardaki kaşıntıya en hızlı gelecek yöntem ve bilinmeyenler…
BOĞAZ VE KULAK BORUSU KAŞINTISI NASIL GEÇER?
Boğaz ve kulak borusunda ortaya çıkan kaşıntı birçok nedene bağlı olarak kendini gösterir. Boğaz kaşıntısı, alerji, enfeksiyon, tahriş, sigara veya susuzluk gibi faktörlerin neden olduğu, kişiyi konuşurken rahatsız eden ve gıdıklanma hissi oluşturan bir problemdir.

Diğer yandan kulak kaşıntısı ise enfeksiyon, otomikoz, kulaklarda kuruluk, kulak kiri tıkanıklığı, işitme cihazları, alerji ve orta kulak iltihabı gibi faktörlerin neden olduğu, son derece rahatsız edici fakat çoğunlukla zararlı olmayan yaygın bir sağlık sorunudur.

Boğaz ve kulak borusu kaşıntısının başlıca belirtileri alerji, enfeksiyon ve virüslerdir. Son zamanlarda artan hastalıklarla birlikte boğaz ve kulak borusundaki kaşıntılarda ciddi oranda artış gösterebiliyor. Boğaz ve burun kaşıntısı özellikle enfeksiyona bağlı hastalıklarla kendini gösterdiğinde çok daha ciddi bir hal alabiliyor.

Hem boğazda hem de kulaklarda rahatsız edici bir his oluşturarak meydana gelen bu kaşıntı, bireyin konuşmasını zorlaştırıyor ve günlük yaşantısını olumsuz yönde etkiliyor. Kulak kaşıntısı, beraberinde ciltte pullanma problemlerini de getiriyor.

Bu noktada boğaz ve kulak borusu kaşıntılarına doğru müdahaleler edilmediğinde; boğaz ve kulaklarda aşınma ve çeşitli olumsuzluklar karşımıza çıkabiliyor. Genellikle kişinin hazırladığı doğal yöntemler sonucu iyileşebilen boğaz ve kulak borusu kaşıntısına iyi gelen birçok farklı yöntem bulunuyor.

BOĞAZ VE KULAK KAŞINTISINA EN HIZLI GELEN YÖNTEM!
Bir türlü geçmek bilmeyen boğaz ve kulak borusu kaşıntısında tıbbi bir müdahaleye ihtiyaç olabilir. Bu doğrultuda kulak burun boğaz doktoruna mutlaka görülmeli ve şikayetinizi bildirmelisiniz. Kısa süreli boğaz ve kulak kaşıntılarını ise evde kolayca uygulayabileceğiniz yöntemlerle geçirebilirsiniz. Peki, boğaz ve kulak kaşıntısına en hızlı gelen yöntem hangisi? Boğaz ve kulak kaşıntısına iyi gelen birçok doğal yöntem bulunmaktadır.

Boğaz ve kulak kaşıntısının giderilmesindeki en etkili yöntem altta yatan nedenin tespit edilmesidir. Kaşıntıya neden olan yönteme göre bir tedavi yöntemi belirlemek, en etkili yöntemler arasında yer alacaktır. Kaşıntıya en hızlı iyi gelen yöntemlerin birçoğu aşağıdaki gibidir…

- Tuzlu su ile gargara yapmak
- Bol sıvı tüketmek
- Sıcak çorba içmek
- Bal tüketimini sınırlı ölçüde artırmak
- Bal ve limonlu zencefil çayı içmek
- Elma sirkesi tüketmek
- Kuru havayı engellemek için nemlendirici kullanmak
- Ağız hijyenini ihmal etmemek
- Sıcak bir duş almak
Bu noktada yukarıdaki yöntemlerin çoğu boğaz kaşıntısını engellemeye yardımcı olur. Aynı zamanda kulak kaşıntısına da etki eder. Fakat kulaklarda oluşan kaşıntı için altında yatan nedene bağlı olarak daha çok tıbbi bir müdahale gerekebilir.